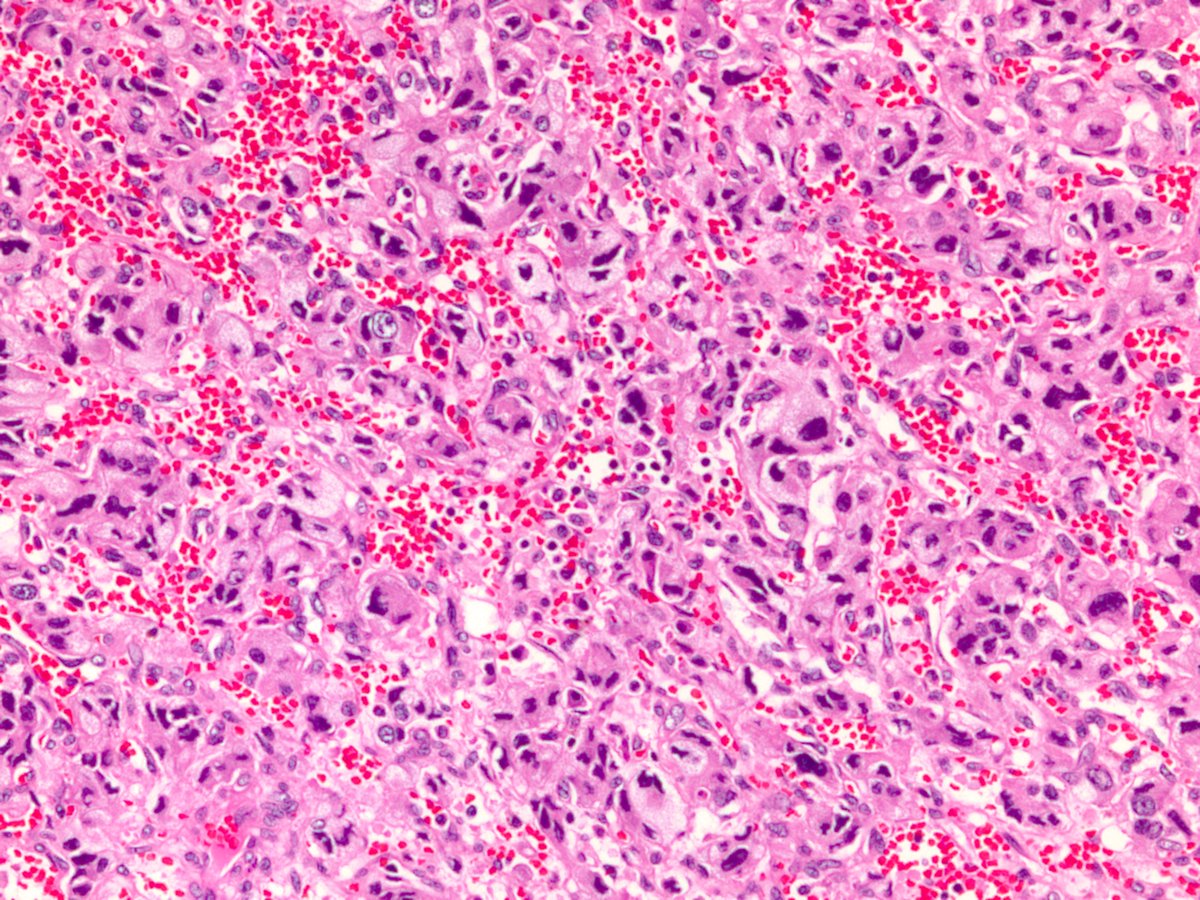
S-100. There's one other stain you should perform to rule out a particular syndrome, but first...please name another neural crest tumor from the adrenal gland.

Is this a:
Paraganglioma...showing the nested "zellballen" growth pattern with vascularized fibrous stroma. We use synapto/chromo/CD56 to highlight tumor cells. Sustentacular cells are often present but are unfortunately not seen in this example. What do sustentacular cells stain with?
S-100. There's one other stain you should perform to rule out a particular syndrome, but first...please name another neural crest tumor from the adrenal gland.
If neuroendocrine markers are positive, what could this be?
Patients with hereditary paraganglioma-pheochromocytoma syndrome have a mutation in which gene?
Succinate dehydrogenase (SDH): a mitochondrial enzyme that converts succinate to fumarate -- Krebs cycle PTSD, anyone? Note that PGL/Pheo syndrome can also arise in the setting of VHL, MEN2, NF1 mutations. Below is our SDH stain, which should be lost in syndromic patients.
However, SDH-deficiency isn't limited to neuroendocrine tumors. Which of the following also have an SDH-deficient subtype?
RCC and GIST! I don't have an SDH-def GIST, but below is an SDH-deficient RCC. These have variable growth patterns, but the intracytoplasmic vacuoles or flocculent inclusions make this tumor look a little bubbly.

 Read on Twitter
Read on Twitter